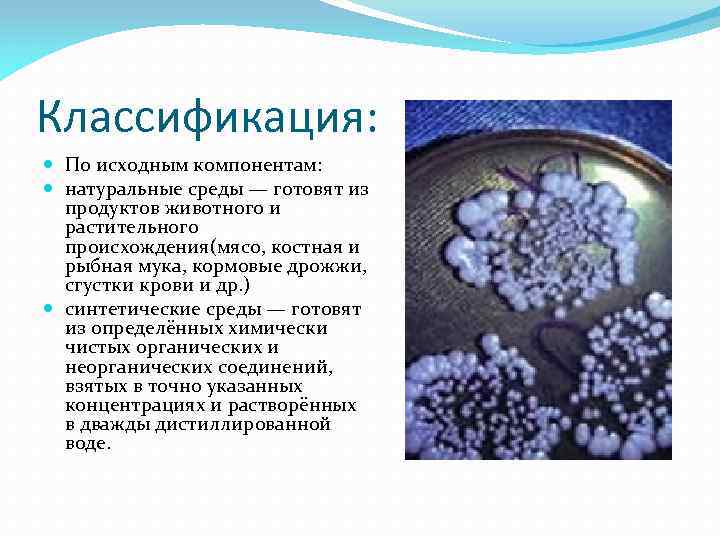
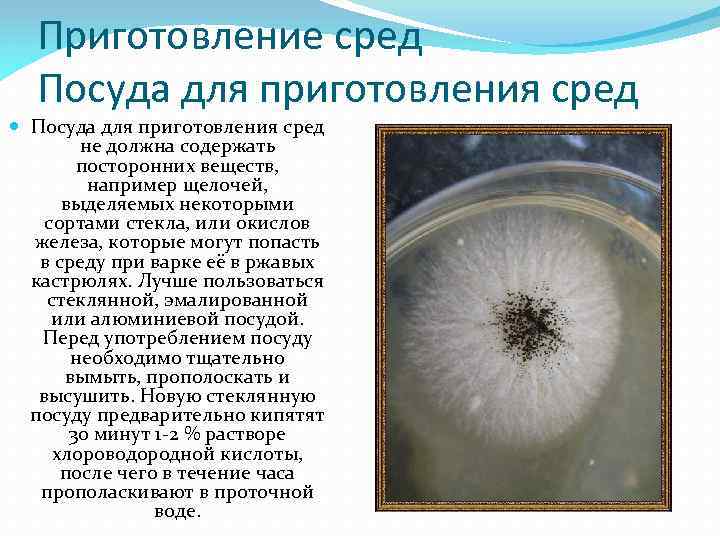

Приготовление питательных сред.pptx
- Количество слайдов: 16
 Приготовление питательных сред Подготовила: учащаяся 4 курса, группы МДД-101 Мычко Вероника Александровна
Приготовление питательных сред Подготовила: учащаяся 4 курса, группы МДД-101 Мычко Вероника Александровна
 Питательная среда — вещество или смесь веществ, применяемая для культивирования макро- и микроорганизмов. Существует множество стандартных биологических питательных сред. Требования, предъявляемые к средам: должны быть питательными, то есть содержать в легко усвояемом виде все вещества, необходимые для удовлетворения пищевых и энергетических потребностей.
Питательная среда — вещество или смесь веществ, применяемая для культивирования макро- и микроорганизмов. Существует множество стандартных биологических питательных сред. Требования, предъявляемые к средам: должны быть питательными, то есть содержать в легко усвояемом виде все вещества, необходимые для удовлетворения пищевых и энергетических потребностей.
 При культивировании ряда микроорганизмов в среды вносят факторы роста — витамины, некоторые аминокислоты, которые клетка не может синтезировать.
При культивировании ряда микроорганизмов в среды вносят факторы роста — витамины, некоторые аминокислоты, которые клетка не может синтезировать.
 Реакция сред Для большинства патогенных бактерий оптимальна слабощелочная среда (p. H 7, 27, 4). Исключение составляют холерный вибрион — его оптимум находится в щелочной зоне (p. H 8, 5 -9, 0) и возбудитель туберкулёза, нуждающийся в слабокислой реакции (p. H 6, 2 -6, 8).
Реакция сред Для большинства патогенных бактерий оптимальна слабощелочная среда (p. H 7, 27, 4). Исключение составляют холерный вибрион — его оптимум находится в щелочной зоне (p. H 8, 5 -9, 0) и возбудитель туберкулёза, нуждающийся в слабокислой реакции (p. H 6, 2 -6, 8).
 быть изотоничными для микробной клетки; то есть осмотическое давление в среде должно быть таким же, как внутри клетки. Для большинства микроорганизмов оптимальная среда, соответствующая 0, 5 % раствору натрия хлорида. быть стерильными, так как посторонние микробы препятствуют росту изучаемого микроба, определению его свойств и изменяют свойства среды.
быть изотоничными для микробной клетки; то есть осмотическое давление в среде должно быть таким же, как внутри клетки. Для большинства микроорганизмов оптимальная среда, соответствующая 0, 5 % раствору натрия хлорида. быть стерильными, так как посторонние микробы препятствуют росту изучаемого микроба, определению его свойств и изменяют свойства среды.
Классификация: По исходным компонентам: натуральные среды — готовят из продуктов животного и растительного происхождения(мясо, костная и рыбная мука, кормовые дрожжи, сгустки крови и др. ) синтетические среды — готовят из определённых химически чистых органических и неорганических соединений, взятых в точно указанных концентрациях и растворённых в дважды дистиллированной воде.
Классификация: По исходным компонентам: натуральные среды — готовят из продуктов животного и растительного происхождения(мясо, костная и рыбная мука, кормовые дрожжи, сгустки крови и др. ) синтетические среды — готовят из определённых химически чистых органических и неорганических соединений, взятых в точно указанных концентрациях и растворённых в дважды дистиллированной воде.
 По консистенции (степени плотности): жидкие полужидкие плотные Плотные и полужидкие среды готовят из жидких, к которым прибавляют агар-агар или желатин. Кроме того, в качестве плотных сред применяют свёрнутую сыворотку крови, свёрнутые яйца, картофель, среды с силикагелем. Некоторые микроорганизмы используют желатин как питательное вещество — при их росте среда разжижается.
По консистенции (степени плотности): жидкие полужидкие плотные Плотные и полужидкие среды готовят из жидких, к которым прибавляют агар-агар или желатин. Кроме того, в качестве плотных сред применяют свёрнутую сыворотку крови, свёрнутые яйца, картофель, среды с силикагелем. Некоторые микроорганизмы используют желатин как питательное вещество — при их росте среда разжижается.
 По составу: простые: мясопептонный бульон(МПБ), мясопептонный агар(МПА), , питательный желатин, сложные — готовят прибавляя к простым средам кровь, сыворотку, углеводы и другие вещества.
По составу: простые: мясопептонный бульон(МПБ), мясопептонный агар(МПА), , питательный желатин, сложные — готовят прибавляя к простым средам кровь, сыворотку, углеводы и другие вещества.
 По назначению: специальные — служат для выделения и выращивания микроорганизмов, не растущих на простых средах. селлективные(избирательные) — служат для выделения определённого вида микробов, росту которых они благоприятствуют, задерживая или подавляя рост сопутствующих микроорганизмов. Среды становятся селлективными при добавлении к ним определённых антибиотиков, солей, изменения p. H. Жидкие элективные среды называют средами накопления. дифференциально-диагностические — позволяют отличить один вид микробов от другого по ферментативной активности. консервирующие — предназначены для первичного посева и транспортировки исследуемого материала.
По назначению: специальные — служат для выделения и выращивания микроорганизмов, не растущих на простых средах. селлективные(избирательные) — служат для выделения определённого вида микробов, росту которых они благоприятствуют, задерживая или подавляя рост сопутствующих микроорганизмов. Среды становятся селлективными при добавлении к ним определённых антибиотиков, солей, изменения p. H. Жидкие элективные среды называют средами накопления. дифференциально-диагностические — позволяют отличить один вид микробов от другого по ферментативной активности. консервирующие — предназначены для первичного посева и транспортировки исследуемого материала.
Приготовление сред Посуда для приготовления сред не должна содержать посторонних веществ, например щелочей, выделяемых некоторыми сортами стекла, или окислов железа, которые могут попасть в среду при варке её в ржавых кастрюлях. Лучше пользоваться стеклянной, эмалированной или алюминиевой посудой. Перед употреблением посуду необходимо тщательно вымыть, прополоскать и высушить. Новую стеклянную посуду предварительно кипятят 30 минут 1 -2 % растворе хлороводородной кислоты, после чего в течение часа прополаскивают в проточной воде.
Приготовление сред Посуда для приготовления сред не должна содержать посторонних веществ, например щелочей, выделяемых некоторыми сортами стекла, или окислов железа, которые могут попасть в среду при варке её в ржавых кастрюлях. Лучше пользоваться стеклянной, эмалированной или алюминиевой посудой. Перед употреблением посуду необходимо тщательно вымыть, прополоскать и высушить. Новую стеклянную посуду предварительно кипятят 30 минут 1 -2 % растворе хлороводородной кислоты, после чего в течение часа прополаскивают в проточной воде.
 Сырьё Исходным сырьём для приготовления большинства сред служат продукты животного и растительного происхождения, а также готовые полуфабрикаты.
Сырьё Исходным сырьём для приготовления большинства сред служат продукты животного и растительного происхождения, а также готовые полуфабрикаты.
 Этапы приготовления варка: среды варят на открытом огне, водяной бане, автоклаве или варочных котлах. установление p. H: ориентировочно производят с помощью индикаторной бумаги, для точного определения пользуются потенциометром или компаратором. При стерилизации p. H снижается на 0, 2, поэтому сначала готовят более щелочной раствор.
Этапы приготовления варка: среды варят на открытом огне, водяной бане, автоклаве или варочных котлах. установление p. H: ориентировочно производят с помощью индикаторной бумаги, для точного определения пользуются потенциометром или компаратором. При стерилизации p. H снижается на 0, 2, поэтому сначала готовят более щелочной раствор.
 осветление производят, если при варке среды мутнеют или темнеют. Для этого используют белок куриного яйца или сыворотку крови. фильтрация жидких и расплавленных желатиновых сред производят через влажный бумажный или матерчатый фильтры. Фильтрация агаровых сред затруднена — они быстро застывают. Обычно их фильтруют через ватно-марлевый фильтр.
осветление производят, если при варке среды мутнеют или темнеют. Для этого используют белок куриного яйца или сыворотку крови. фильтрация жидких и расплавленных желатиновых сред производят через влажный бумажный или матерчатый фильтры. Фильтрация агаровых сред затруднена — они быстро застывают. Обычно их фильтруют через ватно-марлевый фильтр.
 разливают среды не более чем на ¾ емкости, так как при стерилизации могут намокнуть пробки и среды утратят стерильность.
разливают среды не более чем на ¾ емкости, так как при стерилизации могут намокнуть пробки и среды утратят стерильность.
 стерилизация: режим стерилизации зависит от состава среды и указан в её рецепте. контроль для контроля стерильности среды ставят на 2 суток в термостат, после чего их просматривают. химический контроль окончательно устанавливает p. H, содержание общего и амминого азота, пептона, хлоридов. для биологического контроля несколько образцов среды засевают специально подобранными культурами, и по их росту судят о питательных свойствах среды.
стерилизация: режим стерилизации зависит от состава среды и указан в её рецепте. контроль для контроля стерильности среды ставят на 2 суток в термостат, после чего их просматривают. химический контроль окончательно устанавливает p. H, содержание общего и амминого азота, пептона, хлоридов. для биологического контроля несколько образцов среды засевают специально подобранными культурами, и по их росту судят о питательных свойствах среды.
 Спасибо за внимание!
Спасибо за внимание!


